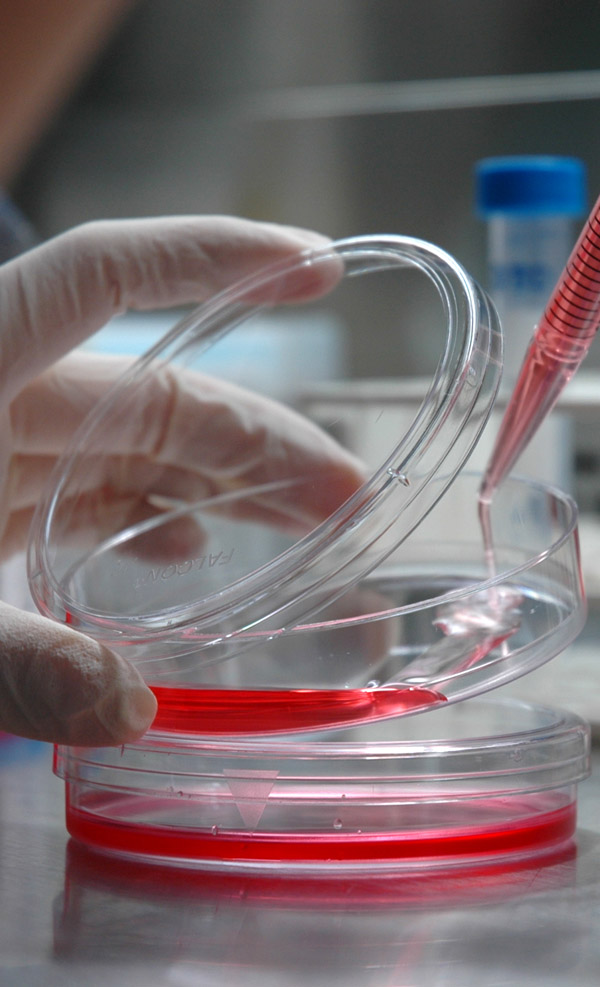

¿QUÉ SON LAS CÉLULAS MADRE DENTALES?
Son un tipo de células madre denominadas “Mesenquimales” que se encuentran en la pulpa de los dientes primarios y permanentes . Estas células Madre tienen como finalidad reemplazar las células enfermas y disfuncionales por células saludables y funcionales. Por su potencial de diferenciación y reproducción, las células Madre Mesenquimales están en investigación para tratar condiciones como:
- Cirugía Plástica y Reconstructiva
- Enfermedades Neurodegenerativas
- Mal de Parkinson
- Alzheimer
- Accidente cerebral - vascular
- Esclerosis Múltiple
- Problemas Odontológicos
- Regeneración de dientes
- Enfermedad Periodontal
- Quemaduras
- Regeneración de Piel
- Oftalmicos
- Regeneración de Córneas
- Lesiones de Médula Espinal
- Regeneración después de accidentes y lesiones
- Problemas Cardiacos
- Infartos
- Regeneración de Corazón
- Válvulas Cardiacas
- Diabetes
- Tipo I y II
¿QUIENES SON CANDIDATOS PARA CRÍO-PRESERVACIÓN DE CÉLULAS MADRE?
Principalmente son los niños que están cambiando de dentición y los adolescentes en quienes están indicadas las extracciones de las muelas del juicio o premolares por cuestiones de Ortodoncia. Las extracciones tendrán que realizarse bajo un estricto protocolo en el consultorio. En Dentiq nuestros especialistas le darán respuesta a todas las preguntas sobre este servicio de vanguardia y última generación.
